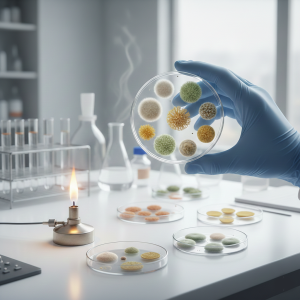
El micólogo de a pie: micología aplicada a laboratorios clínicos. Parte 1

Explorá nuestros talleres y cursos
Cursos y talleres que ofrecemos de manera totalmente virtual, asincrónica y con certificación
Mejorá tus conocimientos
en bioquímica clínica
Podemos ayudarte a alcanzar la excelencia en tu carrera profesional